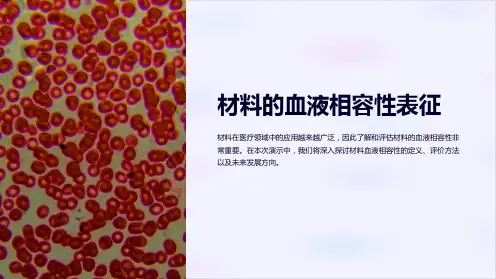

生物材料溶血性标准化评价方法比较_溶血率法和氰化高铁血红蛋白法
- 格式:pdf
- 大小:304.72 KB
- 文档页数:5

氰化高铁血红蛋白测定法氰化高铁血红蛋白测定法是一种常用的生物化学实验方法,用于测定血液中的血红蛋白含量。
本文将介绍这种测定方法的原理、步骤和应用。
一、原理氰化高铁血红蛋白测定法是基于血红蛋白与氰化高铁反应的原理。
血红蛋白是一种含有铁离子的蛋白质,与氰化高铁反应后形成氰合血红蛋白,其吸收波长为540 nm。
通过测定氰合血红蛋白的吸光度,可以间接测定血液中的血红蛋白含量。
二、步骤1. 血样处理:取适量的血液样品,离心分离出血浆,将血浆与氰化高铁试剂混合均匀。
2. 反应:将混合液放入分光光度计或分光比色计中,设定波长为540 nm,记录初始吸光度。
3. 添加还原剂:在反应过程中,加入适量的还原剂,如还原葡萄糖等,使氰合血红蛋白还原成血红蛋白。
4. 再次测定:记录还原后的吸光度。
5. 计算血红蛋白浓度:根据吸光度的变化,利用标准曲线或计算公式,计算出血液中的血红蛋白浓度。
三、应用氰化高铁血红蛋白测定法广泛应用于临床医学和生物研究中。
以下是该方法的几个常见应用:1. 临床诊断:血红蛋白是血液中的重要成分,其测定对于诊断贫血、血液病等疾病具有重要意义。
氰化高铁血红蛋白测定法可以快速、准确地测定血红蛋白含量,帮助医生进行诊断。
2. 药物研发:在药物研发过程中,需要评估药物对血红蛋白的影响。
氰化高铁血红蛋白测定法可以用于评估药物对血红蛋白的结合能力或解离能力,进而判断药物与血红蛋白的相互作用。
3. 营养评估:血红蛋白含量与身体的营养状况密切相关。
通过氰化高铁血红蛋白测定法,可以评估人体的血红蛋白含量,从而判断是否存在营养不良或缺铁性贫血等问题。
4. 动物实验:在动物实验中,血红蛋白的测定对于评估动物的健康状况和实验结果的可靠性至关重要。
氰化高铁血红蛋白测定法可以用于动物血液样品的血红蛋白浓度测定。
氰化高铁血红蛋白测定法是一种常用的测定血红蛋白含量的方法。
其原理简单,步骤明确,应用范围广泛。
在临床医学、药物研发、营养评估和动物实验等领域都有重要的应用价值。

氰化高铁血红蛋白测定法氰化高铁血红蛋白测定法是一种常用的血红蛋白测定方法,通过测定血红蛋白在氰化高铁存在下的吸光度变化,可以定量测定血液中的血红蛋白含量。
本文将详细介绍氰化高铁血红蛋白测定法的原理、步骤、优缺点以及应用等方面内容。
一、原理:氰化高铁血红蛋白测定法是基于血红蛋白与氰化高铁形成氰化高铁血红蛋白(MetHbFe(CN)5)的特点进行测定的。
当血液中存在氰化高铁时,血红蛋白与氰化高铁发生反应,生成氰化高铁血红蛋白,其吸收峰位在630 nm处。
血红蛋白的浓度可以通过测定吸光度来推算。
二、步骤:1. 准备工作:配制所需试剂,包括含氰化高铁的溶液、去离子水等。
2. 标定溶液的制备:用血红蛋白标准溶液制备出不同浓度的标定溶液。
3. 测定样品的制备:取一定量的待测样品,加入适量的氰化高铁溶液进行反应。
4. 吸光度测定:使用分光光度计等仪器,测定标定溶液和待测样品的吸光度。
5. 数据处理:根据吸光度与血红蛋白浓度的关系,计算出待测样品中血红蛋白的浓度。
三、优缺点:1. 优点:(1)灵敏度高:氰化高铁血红蛋白测定法对血红蛋白的检测灵敏度较高,可以提供准确的浓度结果。
(2)操作简便:该方法的操作步骤相对简单,对实验条件的要求较低,适用于临床实验室快速测定血液样品中的血红蛋白含量。
(3)广泛应用:氰化高铁血红蛋白测定法被广泛应用于临床实验室、医疗机构以及科研领域,能够快速准确地测定血液中的血红蛋白含量。
2. 缺点:(1)有毒性:氰化高铁具有一定的毒性,需特别注意在实验过程中的安全操作,避免接触和摄入。
(2)受干扰较大:在应用过程中,有些物质如某些药物、代谢产物等可能会影响测定结果,造成测定误差。
四、应用:氰化高铁血红蛋白测定法广泛应用于临床和研究领域,主要用于以下方面:1. 临床检测:在医疗机构中,血红蛋白含量的测定对于诊断和治疗某些疾病至关重要。
通过氰化高铁血红蛋白测定法,可以快速准确地测定血液中的血红蛋白含量,以辅助疾病的诊断和治疗过程。


氰化高铁血红蛋白测定法试剂氰化高铁血红蛋白测定法是一种常用的生化实验方法,用于分析和测定血液中的血红蛋白含量。
本文将全面介绍该测定法的原理、操作步骤及实验结果的解读,以及实验中需要注意的事项。
氰化高铁血红蛋白测定法的原理是利用氰化高铁与血红蛋白形成氰合血红蛋白,通过测定其最大吸收波长处的吸光度来确定血红蛋白的浓度。
这个测定法在实验室应用广泛,特别适用于快速分析大量样本。
操作步骤如下:1. 准备试剂:将氰化高铁溶液定容至10ml,并使用洗瓶洗净可塑性吸光管。
2. 取1ml待测血清,加入两滴牛磺酸溶液,充分混合。
3. 加入2ml的氰化高铁溶液,尽量避免溶液溢出或产生气泡。
4. 轻轻倾斜吸光管,充分混合后,放置在室温下孵育5分钟。
5. 将孵育后的吸光管置于1cm光程比色皿中,切不可触摸吸光池。
6. 使用5% NaOH溶液分别置于两个比色皿中,作为空白对照。
7. 使用比色计在最大吸收波长(540nm)测定各组的吸光度值。
8. 计算血红蛋白浓度。
根据标定曲线和吸光度值的关系,描绘标定曲线并用所测吸光度值参照标定曲线,查得相应血红蛋白浓度。
实验结果的解读需要注意以下几个方面:1. 血红蛋白浓度的计算:在标定曲线上查找所测吸光度值对应的血红蛋白浓度,可得到最终结果。
2. 结果的参考范围:血红蛋白浓度的正常范围在男性为130~175g/L,女性为115~155g/L。
3. 实验误差的排除:实验过程中,应严格控制各实验条件的一致性,避免外界因素对实验结果的影响。
同时,在同一天内重复检测样本可以提高实验结果的可靠性。
需要注意的事项:1. 操作安全:氰化高铁溶液有毒,操作时应佩戴手套和护目镜,并避免接触皮肤和吸入气体。
2. 实验条件:实验室应具备较好的通风条件,同时实验过程中,避免光线、震动和干扰。
3. 校准和质控:每天开始实验前进行仪器校准,并使用已知浓度的标准品进行质控,以确保实验结果的准确性和可靠性。
综上所述,氰化高铁血红蛋白测定法是一种简便、快速、准确的血红蛋白测定方法。

两种试验方法对一种阳性溶血材料的溶血性能的研究赵增琳;屈秋锦;侯丽;刘香东;董秀丽【摘要】目的:探讨吸光度测定法和血红蛋白浓度测定法两种不同方法对丁腈材料的溶血性能结果的影响,为有效评估医疗器械或材料的溶血性能提供合理的试验方法.方法:采用吸光度测定法和血红蛋白浓度测定法两种方法对丁腈材料进行溶血性能检测,每种方法分别采用直接接触和间接接触两种方式进行,对测得的溶血结果进行比对.结果:直接接触血液时,两种测定方法结果没有差异(P>0.05),为轻度溶血,说明考察试验材料表面接触血液对红细胞的影响时,两种方法中对溶血性能的评价是稳定且一致的.60%浓度稀释液时,虽然结果都在同一判定标准中(都为溶血性),但吸光度测定法溶血率值明显低于血红蛋白浓度测定法(P<0.01).100%浓度浸提液时,吸光度测定法和血红蛋白浓度测定法结果没有差异(P>0.05),均为全部溶血.结论:在实际选择溶血试验方法时,需根据医疗器械临床使用特点,选择适宜的方法考察医疗器械溶血性能.【期刊名称】《中国医疗器械信息》【年(卷),期】2018(024)003【总页数】4页(P5-7,21)【关键词】吸光度测定溶血法;血红蛋白浓度测定溶血法;溶血【作者】赵增琳;屈秋锦;侯丽;刘香东;董秀丽【作者单位】山东省医疗器械产品质量检验中心,山东济南 250101;山东省医疗器械生物学评价重点实验室,山东济南 250101;;;【正文语种】中文【中图分类】R197.39医疗器械/材料的溶血作用是指医疗器械/材料表面或其可溶出物可导致红细胞膜破坏,血浆中游离血红蛋白增加,从而产生的毒性生物学作用。
故医疗器械或材料介导的溶血试验可分为直接接触法和间接接触法。
目前,国际上公认的材料引起的溶血试验方法包括:美国国立卫生院(NIH)吸光度测定法(直接接触法)、美国材料试验协会(ASTM)血红蛋白浓度测定法(直接接触法和间接接触法)[6]。


1、中毒颗粒:在严重感染时中性粒细胞内出现的染成紫黑色的粗大颗粒。
2、杜勒小体:是中性粒细胞胞质因毒性变而保留的嗜碱性区域,呈圆形,梨形或云雾状,界限不清,是胞质局部不成熟,即核与胞质发育不平衡的表现,他亦见于单核细胞中,常见于严重感染。
3.豪-焦小体:成熟红细胞或幼红细胞胞质内含有一个或多个直径为1~2μm暗紫红色圆形小体,为核碎裂、溶解后的残余部分。
常与卡波环同时存在,见于脾切除后、无脾症、脾萎缩、脾功能减低、红白血病、某些贫血(如巨幼红细胞性贫血)4.核左移:外周血中性杆状核粒细胞增多(出现晚、中、早幼粒细胞以致原粒细胞)的现象。
5.核右移:外周血中性分叶核粒细胞增多,并且五叶核以上者超过3%的现象,常见于巨幼贫。
6.网织红细胞:是介于晚幼红细胞和成熟红细胞之间的过渡阶段细胞,略大于成熟红细胞,报纸中残存的嗜碱性物质RNA源自有核红细胞。
RNA是嗜碱性物质,经碱性染料活体染色后,形成蓝色或紫色的点粒状或丝网状结构沉淀物。
7.卡波坏:成熟红细胞内的胞质中出现的紫红色或绕成8字型结构,可能是由于核膜的残余物或纺锤体的残余物及胞质中脂蛋白变性所致,常与染色质小体同时存在。
多见于巨幼细胞贫血,铅中毒,白血病。
8.红细胞沉降率ESR:指红细胞在一定条件下的沉降速度,简称血沉。
9.血细胞比容:只在一定条件下经离心沉淀压实的红细胞在全血中所占体积的百分比。
10.本周氏蛋白:多发性骨髓瘤患者体内产生的免疫球蛋白轻链。
可出现于尿中,该蛋白加热至40~50℃发生沉淀,继续加热则重新溶解。
11.瑞氏染液:是最常用、最经典的血涂片染色的方法,由酸性染料伊红和碱性染料美蓝组成的复合染料。
12.异型淋巴细胞:在某些病毒性感染或过敏原刺激下使淋巴细胞增生,并出现一定的形态变化称为异型淋巴细胞。
13.退行性变白细胞:白细胞出现胞体肿大、结构模糊、边缘不清、核固缩、肿胀或溶解等变化。
14.APTT:是在体外模拟体内内源性凝血的全部条件,测定血浆凝固所需的时间,用以反映内源性凝血因子是否正常,是筛选止血功能最基本常用的试验之一。

生物医学材料评价方法与技术生物医学材料评价方法与技术是研究人工材料在生物环境下性能和安全性的重要领域。
在开发和应用生物医学材料时,评价其生物相容性、生物活性、耐久性和机械性能等是必不可少的环节。
下面将介绍一些常用的生物医学材料评价方法与技术。
一、生物相容性评价方法与技术:1. 细胞毒性测试:通过对生物材料接触所培养的细胞进行毒性评估,了解材料对细胞的影响,包括细胞存活率、细胞形态、增殖能力等。
2. 血凝性评价:材料接触血液后是否引发血凝,可通过凝血时间、纤维蛋白生成等指标来评估材料的血液相容性。
3. 免疫反应评价:测试材料是否会引起机体免疫反应,包括细胞因子释放、炎症反应等指标。
4. 组织相容性评价:将材料植入动物组织内,观察其是否引起组织炎症反应、组织损伤等现象。
二、生物活性评价方法与技术:1. 细胞增殖与分化:通过将材料与培养的细胞接触,观察细胞在材料上的增殖和分化情况,了解材料对细胞的影响。
2. 细胞迁移与黏附:观察材料对细胞迁移和黏附的影响,包括细胞的形态变化、粘附面积等指标。
3. 组织再生:通过植入材料促进受损组织的再生和修复,观察组织再生情况,包括新生组织形态、生物活性物质表达等。
三、耐久性评价方法与技术:1. 材料降解评价:观察材料在生物环境中的降解速度和产物,包括质量损失、元素析出等指标。
2. 力学性能评价:测试材料的力学性能,包括强度、韧性、模量等指标。
3. 长期稳定性评价:通过长时间的体外或体内实验,观察材料的稳定性,并对其性能变化进行分析、比较。
四、表面性能评价方法与技术:1. 表面形貌观察:使用电子显微镜等仪器观察材料表面形貌,了解其表面的粗糙度、孔洞形成等。
2. 表面化学性质:通过测试材料表面的化学成分以及化学反应能力来评估其表面性质。
3. 表面润湿性:通过接触角等指标来评价材料表面的润湿性能,了解其与生物液体的相互作用。
综上所述,生物医学材料评价方法与技术包括生物相容性、生物活性、耐久性和表面性能等方面的评估。


氰化高铁血红蛋白测定法简介目录•1拼音•2英文参考•3概述•4氰化高铁血红蛋白测定法的别名•5分类•6取材•7氰化高铁血红蛋白测定法的原理•8试剂•9操作方法•10正常值•11化验结果临床意义•12附注•13相关疾病1拼音qíng huà gāo tiě xuè hóng dàn bái cè dìng fǎ2英文参考cyanmethemoglobin determination method3概述Hb测定大致分为:①根据Hb分子组成,测定总Hb法(全血铁法);②根据血液物理特性测Hb(比重法、折射仪法);③根据Hb 与O2可逆性结合的特性测Hb(血气分折法);④根据Hb衍生物光谱特点进行的定量测定等4大类,其中有些方法简单易行,而得到长期广泛应用(如沙利法),但随着技术的进步和研究的深入,缺点日渐显著,逐渐被淘汰。
为统一Hb测定方法,1966年国际血液学标准化委员会推荐氰化高铁Hb测定法作为Hb测定标准法。
1978年国际临床化学联合会和世界病理学会联合发表的国际性文件中重申了HiCN 法。
4氰化高铁血红蛋白测定法的别名氰化高铁Hb测定法5分类临床血液检查 > 红细胞6取材血液7氰化高铁血红蛋白测定法的原理血液在Hb转化液中溶血后,除SHb外各种Hb均可被高铁氰化钾氧化为高铁Hb再与CN结合生成稳定的棕红色氰化高铁Hb。
HiCN 最*** 峰在540nm,最小吸收峰为504nm。
特定标准条件下,毫摩尔消光系数为44L·mmol-1·cm。
因此,根据标本的吸光度,即可测定Hb浓度。
在没有符合WHO标准的分光光度计的条件下,亦可用HiCN参考液制标准曲线,或计算出换算常数,间接计算Hb浓度(g/L)。
HiCN的消光系数是44mmol-1·cm-1,可根据下列公式进行计算Hb浓度:A/44×64458(mg)/1000×251=A×367.7=Hb(g/L)式中A是在540nm处HiCN吸光度,64458mg是Hb的毫克分子量,1000是将毫克转换为克,251是实验时血液的稀释倍数。
生物材料溶血性标准化评价方法比较:溶血率法和氰化高铁血红蛋白法张伶俐 朱蔚精 谭言飞 屈树新 张兴栋△(四川大学分析测试中心生物学评价实验室,生物材料工程研究中心,成都 610064) 摘要 采用游离血红蛋白直接测定法即溶血率测定法(根据ISO TR7405)和氰化高铁血红蛋白法(根据ISO 1099324)测定了羟基磷灰石(陶瓷)和胶原(高分子材料)的溶血性能,结果提示这两种方法的结论是一致的,且氰化高铁血红蛋白法较血红蛋白直接测定法有灵敏、稳定、可比性好等优点,值得推广应用。
但它存在着一些标准中尚未明确规定的问题。
作者在大量试验和不违背标准原则的基础上提出了一些改进意见,使它更具有可操作性,以便于标准化评价生物材料的溶血性能。
关键词 生物学评价 血液相容性 溶血试验Com par ison between Hem olysis Percen tage M ea surem en t and Hem iglob i ncyan ide M ea surem en t for Standard iz i ng the Eva lua tion ofHem olytic Properties of B ioma ter i a lsZhang L i ngl i Zhu W e ij i ng Tan Yanfe i Qu Shux i n Zhang X i ngdong∃(B iolog ica l E va lua tion L aborota ry,A na ly sis and T esting Cen ter,E ng ineering R eseach Cen ter in B io m a teria ls,S ichuan U n iversity,Cheng d u 610064,Ch ina) Abstract In th is study,tw o m ethods——the supernatant hemoglobin spectropho tom etry,i.e.hemo lysis percentage m easurem ent(acco rding to ISO TR7405)and the hem iglobincyanide m easurem ent(acco rding to ISO 1099324)——w ere used to assay the hemo lytic p roperties of hydroxyapatite(bi oceram ics)and co llagen(po lym er).T he results show ed that the conclusi ons draw n from using the tw o m ethods w ere basically consistent,and the lat2 ter w as mo re sensitive,stable and comparable.How ever,som e of the p rocedures in the hem iglobincyanide m ethod w ere no t defined in details.So based on our experi m ents w e have offered som e suggesti ons and i m p rovem ents, w h ich do no t deviate from ISO and A STM standards,fo r h iher p racticability of usig it in standardizing the evalua2 ti on of the hemo lytic p roperties of bi om aterials.H em iglobincyanide m easurem ent is w o rthy of w ider app licati on.Key words B i o logical evaluati on H emocompatibility H emo lysis test1 引 言与血液直接或间接接触的生物材料必须评价它的血液相容性。
氰化高铁法第一篇:氰化高铁法原理:血红蛋白在高铁氰化钾和氰化钾的作用下,生成极为稳定的氰化高铁血红蛋白(红色),其颜色深浅与血红蛋白的含量成正比。
氰化高铁血红蛋白在540 nm 波长下,毫克分子消光系数为44 ,据此,用分光光度法测其吸光度,运用消光系数作血红蛋白的定量测定,其化学反应式如下: 血红蛋白——铁氰化钾——高铁血红蛋白——氰化钾——氰化高铁血红蛋白(红色)试剂: 碳酸氢钠(NaHCO3)140 mg ,铁氰化钾[ K3 Fe(CN)6 ]200 mg ,氰化钾(KCN)50 mg ,均为分析纯。
用水溶解并稀释到1 000 mg ,贮存于棕色试剂瓶内,在暗处或冰箱(4 ℃)保存,至少可稳定数月到1 年。
操作步骤: ①取试剂2.5 mL 于5 mL 带盖试管中加入10μL 血液,混匀后,放置15 min。
②选用0.5 cm 光径比色杯,于540 mm 波长下,以试剂调零点,将所得样品管之吸光度乘以73.6 ,即为血红蛋白之浓度。
计算公式如下: Ct =(D540HiCN ×251/ 44 ×0.5)×64 458/ 10 000 = 73.6 ×吸光度。
Ct 为待测的血红蛋白浓度。
D540HiCN为氰化高铁血红蛋白在540 mm 波长下测出的吸光度。
251 为测定时血液的稀释倍数(10μL 血加入215 mL 试剂中)。
44 为氰化高铁血红蛋白的毫克分子消光系数。
0.5 为比色杯的光径。
64 458 为血红蛋白的相对分子质量。
第二篇:氰化技术主管竞聘稿做氰化技术的排头兵尊敬的各位领导、各位评委老师您们好:我叫XXX,我竞聘的岗位是青海山金氰冶技术主管。
我将从个人简介、任职优势、工作思路几方面进行竞聘演讲,希望能得到大家的支持。
一、个人简介1.工作经历二、我的任职优势1、经验使我对氰化技术工作得心应手对于氰化、氧化系统,我做过每个工段操作工。
二十多年一路干过来,我掌握的技术都是实打实的,流程哪个环节出现问题、哪个设备出现异常会带来什么后果,我都能在第一时间找出原因和解决办法,也由于这个原因,来此之前任莱州市治炼厂氰化厂副帮长。
医疗器械溶血性能三种评价方法的比较乔春霞;侯丽;赵增琳;王贤美;范春光;孙立魁;于兆琴【期刊名称】《中国医疗器械信息》【年(卷),期】2013(000)007【摘要】与血液接触的医疗器械和材料在临床前的安全性评价中经常要进行直接和/或间接溶血试验。
目前使用频率较高的溶血试验方法主要有三种:NIH法、ASTM法和MHLW法。
虽然三种方法在国际上常规评价医疗器械/材料溶血性能方面得到广泛认可,但是缺乏对三种方法进行比较研究的数据。
目前ISO/TC 194工作组正在组织溶血Round robin(国际比对)试验,但是具体的试验草案还在完善当中。
文章从原理、血源、方法和结果判定等方面对此三种方法进行了全面介绍,为Round robin试验提供理论方面的帮助。
【总页数】5页(P61-65)【作者】乔春霞;侯丽;赵增琳;王贤美;范春光;孙立魁;于兆琴【作者单位】国家食品药品监督管理局济南医疗器械质量监督检验中心,山东省医疗器械生物学评价重点实验室济南市 250101;国家食品药品监督管理局济南医疗器械质量监督检验中心,山东省医疗器械生物学评价重点实验室济南市 250101;国家食品药品监督管理局济南医疗器械质量监督检验中心,山东省医疗器械生物学评价重点实验室济南市 250101;国家食品药品监督管理局济南医疗器械质量监督检验中心,山东省医疗器械生物学评价重点实验室济南市 250101;国家食品药品监督管理局济南医疗器械质量监督检验中心,山东省医疗器械生物学评价重点实验室济南市 250101;国家食品药品监督管理局济南医疗器械质量监督检验中心,山东省医疗器械生物学评价重点实验室济南市 250101;国家食品药品监督管理局济南医疗器械质量监督检验中心,山东省医疗器械生物学评价重点实验室济南市250101【正文语种】中文【中图分类】R197.39【相关文献】1.医疗器械溶血性能评价方法-NIH法的直接接触法和间接接触法比较 [J], 乔春霞;屈秋锦;赵增琳;侯丽;杨婧;董秀丽2.医疗器械溶血性能评价方法-ASTM直接接触法和间接接触法的比较 [J], 乔春霞;侯丽;赵增琳3.国内外医疗器械软件安全性评价方法比较研究 [J], 王茜;竺林4.国内外医疗器械软件安全性评价方法比较研究 [J], 王茜; 竺林5.生物材料溶血性标准化评价方法比较:溶血率法和氰化高铁血红蛋白法 [J], 张伶俐;朱蔚精;谭言飞;屈树新;张兴栋因版权原因,仅展示原文概要,查看原文内容请购买。
血红蛋白的测定方法血红蛋白是一种色素蛋白,可以用比色法测定。
血液中血红蛋白以各种形式存在,包括氧合血红蛋白、碳氧血红蛋白、高铁血红蛋白或其他衍生物。
1)氰化高铁血红蛋白(HiCN)测定法:血液中除了SHb以外,其他各种血红蛋白均可被试剂转化、生成HiCN,其最大的吸收峰为540nm波长,可经比色测定。
此法为国际血液学标准化委员会(ICSH)推荐的国际标准参考方法,操作简单,显色快且结果稳定医`学教育网搜集整理;但本法试剂中KCN有剧毒,测定过程中高白细胞和高球蛋白血症易致混浊,HbCO转化较慢。
2)十二烷基月桂酰硫酸钠血红蛋白(SLS-Hb)法:除SHb外,血液中各种Hb均可与低浓度十二烷基月桂酰硫酸钠(SLS)作用,生成SLS-Hb棕红色化合物。
SLS-Hb最大吸收波峰538nm,波谷500nm,肩峰560nm.由于摩尔消光系数尚未最后确认,因此不能用吸光度“A”值直接计算血红蛋白浓度。
本法操作简单,呈色稳定,准确性和精确性符合要求,且无公害。
但SDS质量差异较大,并且SDS可破坏白细胞,不适合进行白细胞计数的血液分析仪使用。
3)叠氮高铁血红蛋白(HiN3)测定法:与HiCN法相似,但仍然有公害问题。
4)碱羟血红蛋白(AHD 575nm)测定法:试剂简单、不含有毒试剂、呈色稳定,但由于其吸收峰在575nm,限制了此法在血液分析仪的使用。
5)溴代十六烷基三甲胺(CTAB)血红蛋白测定法:该法试剂溶血性强又不破坏白细胞,可同时进行白细胞计数,可用于血细胞分析仪自动检测Hb和白细胞。
缺点是对Hb测定结果的准确度和精密度较低。
近年来,多参数血细胞分析仪的应用,使Hb测定逐步以仪器法取代手工法,其优点是操作简单、快速,同时可以获得多项红细胞的参数,血液分析仪法测定血红蛋白的原理与手工法原理相似,多采用HiCN法,但由于各型号仪器使用的溶血剂不同,形成Hb的衍生物不同医`学教育网搜集整理。
某些溶血剂形成的衍生物稳定性较差,因此要严格控制溶血剂加入量及溶血时间,特别是半自动血细胞分析仪应严格控制实验条件。
医疗器械溶血性能评价方法-NIH法的直接接触法和间接接触法比较乔春霞;屈秋锦;赵增琳;侯丽;杨婧;董秀丽【摘要】根据ISO/TC194WG9的要求进行溶血比对(Round robin)试验.采用NIH(National Institutes of Health,美国国立卫生研究院)直接接触法和间接接触法测定了5种材料的溶血性能,结果显示聚乙烯、丁腈手套、#1橡胶和#2橡胶的溶血等级判定结果在两种方法是一致的,但是丁腈手套的两种方法的溶血率值有显著差异.乳胶手套的溶血率和判定结果不一致.作者分析了这些不一致产生的原因,为医疗器械或材料的溶血性能检测提出了一些建议,为新标准的发布和实施提供数据支持.【期刊名称】《中国医疗器械信息》【年(卷),期】2017(023)017【总页数】3页(P42-43,52)【关键词】医疗器械;溶血性能;NIH方法【作者】乔春霞;屈秋锦;赵增琳;侯丽;杨婧;董秀丽【作者单位】国家食品药品监督管理局济南医疗器械质量监督检验中心;山东省医疗器械生物学评价重点实验室山东济南 250101;山东恒信检测技术开发中心山东济南 250101;山东恒信检测技术开发中心山东济南 250101;国家食品药品监督管理局济南医疗器械质量监督检验中心;山东省医疗器械生物学评价重点实验室山东济南 250101;山东恒信检测技术开发中心山东济南 250101;山东恒信检测技术开发中心山东济南 250101【正文语种】中文【中图分类】R197.39医疗器械本身或使用不当可能会导致溶血的发生,从而为临床带来一些不利的影响,因此评价医疗器械的溶血性能是很有意义的筛选试验。
国际标准ISO 10993-4:2017(E)[1]中列出了三种试验方法供选择,分别是ASTM(American Society for Testing and Materials,美国材料与试验协会)F756-08[2]、NIH[3]和MHLW[4](日本劳动健康福利局)发布的关于溶血的方法。
两种试验方法评价可吸收医疗器械溶血性能的比较
姚瑶
【期刊名称】《现代仪器与医疗》
【年(卷),期】2022(28)5
【摘要】目的使用两种试验方法评价可吸收医疗器械的溶血性能,并对其结果是否一致进行探讨,分析存在差异的原因。
方法选取六种可吸收医疗器械,按
GB/T16886.12推荐的浸提比例,采用生理盐水作为浸提介质,分别使用直接接触法和间接接触法评价其溶血性能,并比较实验终点浸提液pH变化。
结果医用可吸收缝合线(PGLA)、医用可吸收止血纱布(氧化再生纤维素)、可降解药物洗脱支架(PDLGA)三组样品采用两种方法检测时溶血率有显著性差异(P<0.01)。
结论在本实验条件下,材料和或其降解产物偏酸性、含药器械药物的释放是引起溶血率升高的主要因素,建议同时使用直接接触法和间接接触法评价可吸收医疗器械或材料的溶血性能。
【总页数】4页(P18-21)
【作者】姚瑶
【作者单位】上海市医疗器械检验研究院
【正文语种】中文
【中图分类】TH789
【相关文献】
1.两种试验方法对一种阳性溶血材料的溶血性能的研究
2.医疗器械溶血性能评价方法-NIH法的直接接触法和间接接触法比较
3.医疗器械溶血性能三种评价方法的比较
4.医疗器械溶血性能评价方法-ASTM直接接触法和间接接触法的比较
5.前交叉韧带重建中可吸收螺钉与金属螺钉两种固定方式比较的系统评价
因版权原因,仅展示原文概要,查看原文内容请购买。
生物材料溶血性标准化评价方法比较:溶血率法和氰化高铁血红蛋白法张伶俐 朱蔚精 谭言飞 屈树新 张兴栋△(四川大学分析测试中心生物学评价实验室,生物材料工程研究中心,成都 610064) 摘要 采用游离血红蛋白直接测定法即溶血率测定法(根据ISO TR7405)和氰化高铁血红蛋白法(根据ISO 1099324)测定了羟基磷灰石(陶瓷)和胶原(高分子材料)的溶血性能,结果提示这两种方法的结论是一致的,且氰化高铁血红蛋白法较血红蛋白直接测定法有灵敏、稳定、可比性好等优点,值得推广应用。
但它存在着一些标准中尚未明确规定的问题。
作者在大量试验和不违背标准原则的基础上提出了一些改进意见,使它更具有可操作性,以便于标准化评价生物材料的溶血性能。
关键词 生物学评价 血液相容性 溶血试验Com par ison between Hem olysis Percen tage M ea surem en t and Hem iglob i ncyan ide M ea surem en t for Standard iz i ng the Eva lua tion ofHem olytic Properties of B ioma ter i a lsZhang L i ngl i Zhu W e ij i ng Tan Yanfe i Qu Shux i n Zhang X i ngdong∃(B iolog ica l E va lua tion L aborota ry,A na ly sis and T esting Cen ter,E ng ineering R eseach Cen ter in B io m a teria ls,S ichuan U n iversity,Cheng d u 610064,Ch ina) Abstract In th is study,tw o m ethods——the supernatant hemoglobin spectropho tom etry,i.e.hemo lysis percentage m easurem ent(acco rding to ISO TR7405)and the hem iglobincyanide m easurem ent(acco rding to ISO 1099324)——w ere used to assay the hemo lytic p roperties of hydroxyapatite(bi oceram ics)and co llagen(po lym er).T he results show ed that the conclusi ons draw n from using the tw o m ethods w ere basically consistent,and the lat2 ter w as mo re sensitive,stable and comparable.How ever,som e of the p rocedures in the hem iglobincyanide m ethod w ere no t defined in details.So based on our experi m ents w e have offered som e suggesti ons and i m p rovem ents, w h ich do no t deviate from ISO and A STM standards,fo r h iher p racticability of usig it in standardizing the evalua2 ti on of the hemo lytic p roperties of bi om aterials.H em iglobincyanide m easurem ent is w o rthy of w ider app licati on.Key words B i o logical evaluati on H emocompatibility H emo lysis test1 引 言与血液直接或间接接触的生物材料必须评价它的血液相容性。
溶血试验检测生物材料与红细胞的相互作用,是一项非常重要的血液相容性评价试验,也是一项重要的体外粗筛试验。
目前国内外大多采用游离血红蛋白直接测定法即溶血率测定法评价生物材料的溶血性能[1~6],但国际标准化组织(In ter2 nati onal standard o rgan izati on,ISO)于2000年颁布了ISO D IS1099324:2000标准[7],重点推荐了氰化高铁血红蛋白法(hem iglob incyan ide,H i CN),并指∃联系人。
E2m ail:zhangxd@。
T el:028*********明操作程序参考A STM F756293标准[8]。
为了与国际接轨,我国正在准备出台相应的等同标准(GB T16886.42xxxx[9])。
然而,无论是ISO D IS109932 4:2000还是A STM F756293都还有一些问题没有规定和说明,给这一标准的实施带来一定的困难。
比如A STM F756标准要求用3只兔的血分别进行试验,而ISO D IS1099324:2000要求最好用人血,也可以用三只兔的混合稀释血代替人血,因为动物血中兔的溶血性能与人最接近。
其次,A STM F756293和ISO D IS1099324:2000都没有规定无定形材料的检测用量,等等。
本文对H i CN测定法进行了一些探索,重点分析了不同血液来源和不同材料的测定结果,比较了两种方法的优缺点,并且在不违背标准原则的基础上提出了一些建议,以便更好地贯彻实生物医学工程学杂志J B i om ed Eng 2004;21(1)∶111~114 施新颁布的标准(GB T16886.4)。
2 材料和方法2.1 材料和仪器选择了两大类生物材料。
第一类是羟基磷灰石(H ydroxyap atite,HA)生物陶瓷,白色颗粒状,51 mm,其阴性对照选用氧化铝陶瓷,呈白色砂粒状。
第二类是医用高分子胶原(co llagen),白色片状,厚度大于0.5mm,其阴性对照选用医用输血袋聚氯乙烯(Po lych lo rovinyl,PV C),无色透明片状,厚度小于0.5mm。
新鲜兔血取自附有健康合格证的大耳白兔,人血取自某单位健康体检人群。
可见与紫外分光光度计(UV755B型,上海精密科学仪器有限公司分析仪器总厂制造,中国测试技术研究院检定)被用于本试验。
2.2 氰化高铁血红蛋白法(H i CN法)[7~10]2.2.1 材料的准备 颗粒或砂粒状材料取1g放入一只试管中,蒸馏水洗3次,生理盐水洗3次,生理盐水浸泡5m in,沥干备用。
厚度大于0.5mm的片状材料取15c m2(单面面积),厚度小于0.5mm 的取30c m2(单面面积)放入一只试管中。
每种材料准备6个试管。
2.2.2 血液的准备 抗凝剂用肝素或A CD液(枸橼酸4.7g L,枸橼酸钠13.3g L,葡萄糖30.0g L)。
兔血或人血的血浆游离血红蛋白浓度应小于1.0m g mL。
用生理盐水稀释全血至总血红蛋白浓度小于1.250±0.125m g mL。
另外稀释三只兔的等量混合血,混合血的血浆游离血红蛋白和全血的总血红蛋白浓度均应满足上述要求。
取稀释血1 mL,加入3mL D rabk in’s试剂(碳酸氢钠1.0g L,氰化钾0.05g L,铁氰化钾0.2g L)中,测吸光度(OD540)值,即得1mL稀释血中的总血红蛋白。
2.2.3 材料与血液接触 于每种材料6只试管中各加入5mL稀释全血,轻轻混匀。
6只试管分成两组进行静态试验和动态试验。
静态试验组在37±2℃恒温水浴中静置4h,动态试验组在37±2℃的条件下,置振摇板上振摇混合1h,垂直方向不超过45°,振摇频率为30±6r m in。
2.2.4 吸光度的测定 取出上述试管,以700~800g离心5m in,小心吸取上清液1mL,加入3mL D rabk in’s试剂中,在紫外2可见分光光度计(UV2 755B)上,用D rabk in’s试剂调零,测定540nm波长下的吸光度(OD540)值,光径1c m。
查标准曲线,即得游离血红蛋白浓度。
2.2.5 计算溶血指数(H em o lytic index,H.I.)H.I.=1mL上清液中的游离血红蛋白1mL稀释血中的总血红蛋白2.2.6 结果判断 溶血指数为0~2,不溶血;溶血指数为2~10,轻度溶血;溶血指数为10~20,中度溶血;溶血指数为20~40,明显溶血;溶血指数> 40,重度溶血。
2.3 游离血红蛋白直接测定法[11~14]2.3.1 材料的准备 颗粒或砂粒状材料取5g放入一支试管中,洗涤方法同前。
片状材料厚度大于0.5mm取30c m2(单面面积)放入一支试管中。
阴性对照为生理盐水(0.9%N aC l so lu ti on,N S),阳性对照为蒸馏水,各取10mL装入一支试管中。
材料、阴性对照、阳性对照各准备3只试管。
2.3.2 血液的准备 取一只健康家兔的鲜血2 m l,肝素抗凝,加入2.5m l生理盐水稀释,0.2mL 稀释血在10mL蒸馏水中于波长545nm处的吸光度值应为0.8±0.3。
2.3.3 材料与血液相接触 在3只装有样品的试管中每只加入10mL生理盐水,与阴性对照组和阳性对照组同时放入37±2℃恒温水浴中静置30 m in,加入0.2mL稀释血,再在37±2℃恒温水浴中静置1h。
2.3.4 吸光度的测定 取出上述试管,以700~800g离心5m in。
小心吸取上清液4mL,在紫外2可见分光光度计(UV2755B)上,用生理盐水调零,测定545nm波长下的吸光度(OD545)值,光径1c m。
阴性对照组的吸光度的平均值为D nc,阳性对照组的吸光度的平均值为D pc,样品的吸光度为D t。
计算溶血率Z:Z=D t-D ncD pc-D nc×100%2.3.5 结果判断 试验样品的溶血率应小于5%,若大于5%则预示材料有溶血作用。
3 结 果3.1 H i CN法检测羟基磷灰石陶瓷颗粒的溶血指数首先测定了样品在不同兔血中的溶血指数(结果见表1)。
证实不同个体的兔血对试验结果有影响。
211 生物医学工程学杂志 第21卷表1 HA颗粒与不同个体的兔血接触的H i CN法试验结果Table1 The results of HA i n con tact with differen t rabbit blood by H i CN methodM aterials R abbits H emo lytic indexof static testFo r q PH emo lytic indexof static testFo r q PHA8#36.5±7.214.4<0.0168.5±4.554.2<0.01 13#18.7±0.724.3±3.415#42.3±4.165.8±2.4R abbits22.7±1.9 ①与③23.09<0.0155.0±13.3 ①与③10.01<0.01H um an A5.5±0.0 ①与②18.95<0.0111.3±2.0 ①与②8.48<0.01H um an B3.2±0.7 ②与③4.14<0.056.4±1.4 ②与③1.53>0.05A l2O38#2.2±0.65.27<0.055.6±1.10.35>0.0513#1.5±0.04.5±2.615#4.9±0.88.1±1.6N S8#2.2±1.70.25>0.055.0±1.77.22<0.05 13#1.1±0.04.1±0.715#2.4±1.63.2±1.6 注:①、②、③是按三个组的溶血指数的均数从大到小排列,3HA:hydroxyapatite;H i CN:hem iglobincyanide ISO D IS1099324:2000指出,最好选用人血做溶血实验,也可以用三只兔的混合稀释血液代替人血。